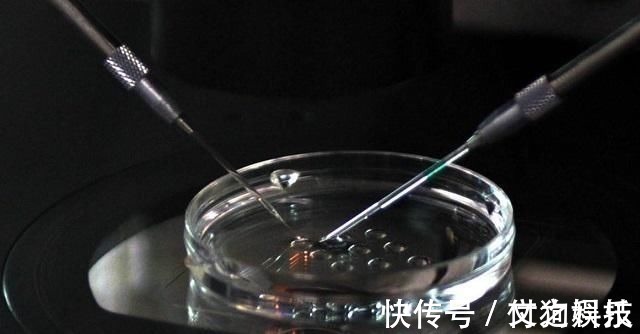
郑女士|国内首例“试管婴儿”,如今已32岁,生活状况在众人意料之外

郑女士|国内首例“试管婴儿”,如今已32岁,生活状况在众人意料之外
她的妈妈正是1988出生的国内首例“试管婴儿”。
30多年前,在很多人看来,试管受精是违背道德的。
很多人不相信“试管婴儿”技术能让不孕的人生下健康的孩子,也没人敢尝试,但甘肃的郑女士,却迈出了这历史性的一步,生下了国内第一个“试管婴儿”。

文章插图
郑女士给女儿取名为“萌珠”,萌珠如今已经32岁了。
与当时很多人所担忧的不同,萌珠的成长过程很健康,与正常妊娠生下的孩子并没有什么不同。

文章插图
长大后,萌珠被医学院录取,现在是一名优秀的医生,在北京三医院任职,这正是当时她出生的医院。
萌珠如今也做了母亲,她有一个健康可爱的孩子。
在试管婴儿技术问世的初期,大多数人都觉得,萌珠这样一个在试管中培育出的孩子是无法活下来的。
但萌珠却用自己的人生向世人证明:“试管婴儿”和普通孩子一样是可以健康成长的。

文章插图
“试管婴儿”技术的意义:
在“试管婴儿”技术还未出现之前,传统观念认为被判定为不孕的女性一辈子都不能拥有自己的孩子。
但”试管婴儿“技术改变了这个观点,很多不孕的女性也能通过这项技术生孩子。
尤其在娱乐圈,很多女明星往往因为高龄难以怀孕,试管技术的成熟让这种问题迎刃而解。

文章插图
这样经过“严格挑选”形成的受精卵也拥有优秀基因的受精卵,孕育出的后代也一定是最健康的后代。
如果夫妻双方都有遗传病史,这样的技术对他们来说无疑是非常有帮助的。
文章插图
【 郑女士|国内首例“试管婴儿”,如今已32岁,生活状况在众人意料之外】以往,因女方不能生育而离婚的例子数不胜数,但“试管婴儿”技术出现之后,就可以让本不能生育的女性生下健康的孩子。
这在无形中提升了女性在婚姻中的地位,不会因为生育问题而单方面被要求离婚。
妻子可以自由选择是否用试管来“培育”一个孩子。

文章插图
做“试管婴儿”的注意事项:
要知道,虽然“试管婴儿”技术日趋成熟,但并不能保证100%的成功,有时候需要尝试很多次后才能生下自己的宝宝。
并且,如果有些父母生活习惯不好,或者不按照医生的指导生活,也可能导致“试管婴儿”畸形。

文章插图
做试管婴儿的女性往往都是高龄难以怀孕,或是因为身体原因不能怀孕,在这种情况的基础上,女性的心理压力本来就会很大。
再加上试管婴儿高额的费用和前期准备的煎熬过程,以及家里老人的满心期待,很容易会导致女性的心理压力过大,从而心态崩塌。
如果女性在处于压力的情况下进行试管婴儿,对身体排卵很不利,卵子的质量也不会太高。

文章插图
所以如果决定了进行试管,那么不论将要面对什么事情,都要保持良好的心态,不要让自己处于低气压的环境里。
- 王女士|8岁姐姐打哭3岁弟弟,父母一旁看热闹哈哈大笑:她比我们会教育
- 徐女士|“若不限生育,你准备生几个娃?”90后的答案,现实又扎心
- 郑姐|吃一次7天不消化,很多父母天天喂娃吃,儿科主任溺爱毁掉孩子
- 王女士|产妇半夜生二胎,产房外只有大女儿一人等候,孩子的话让护士落泪
- 养娃|同是高龄怀孕分娩,68岁田女士和70岁盛海琳现实差距太大,很现实
- 陈女士|真正影响胎儿呼吸顺畅的,是孕妇这些恶习,别让“生命水”被污染
- 孩子|许女士孩子真的医学出生证明给了谁?出生证明难道不是唯一的吗
- 周口|周口、郑州新生儿登记排全国前十
- 分娩|同是高龄怀孕分娩,68岁田女士和70岁盛海琳现实差距太大,很现实
- 疗程|苏女士小脑萎缩,家中奶奶父亲均有相同症状,通过治疗得到改善